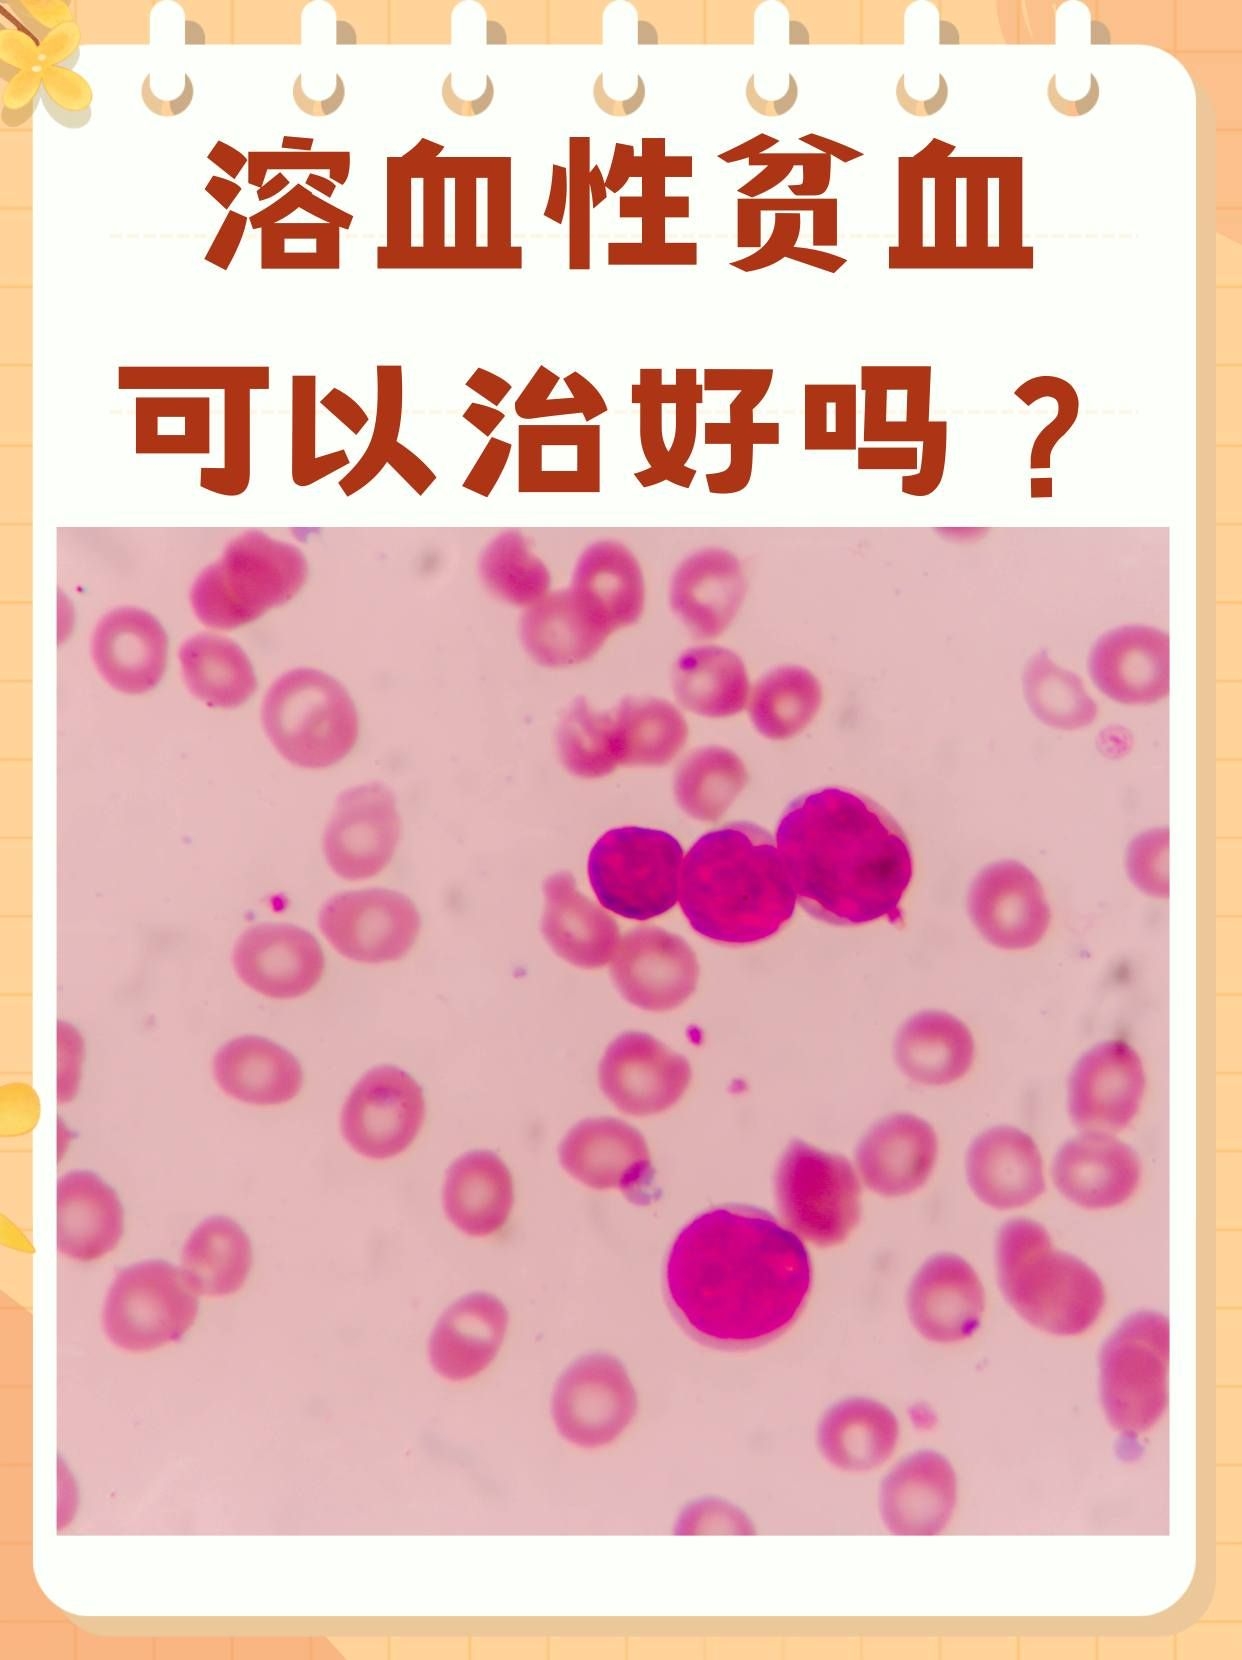

脸上长痘痘,可以吃什么药?(遇到难缠的痘痘)
痤疮(痘痘)带来的痛苦令许多人难以忍受,因此衍生了不少错误的“治疗”方法让大家走了弯路,如双手挤压、针刺、使用清洁力极强的护肤品等,这些方法不仅直接伤害皮肤屏障,还治标不治本。痤疮本身是油脂分泌过多堵塞毛孔加之毛囊炎...
房性心动过速的心电图表现有哪些
1 房颤** 心电图上P波消失,代之以频率约350~600次分的f波 心室率极不规则,通常在100~160次分之间2 房性心动过速** 心电图上P波形态与窦性P波不同,且P波频率通常超过100次分 心室率规则或不规则...
血红细胞偏低的原因是什么
急性失血性贫血如外伤大出血等慢性失血性贫血如消化性溃疡月经过多等长期慢性失血情况当血常规中红细胞值偏低时,应引起重视,因为红细胞负责为人体输送氧和二氧化碳,其值降低可能导致乏力贫血容貌等症状为明确红细胞偏低的具体原因...
2018年上海平均工资
2018年,上海作为中国的经济、金融和商业中心,吸引了大量的外来人口和各类人才。随着上海经济的持续发展,其居民的收入水平也发生了显著变化。2018年上海的平均工资成为了讨论社会经济状况、职场竞争力和生活水平的重要指标...

京公网安备11000000000001号
京ICP备11000001号